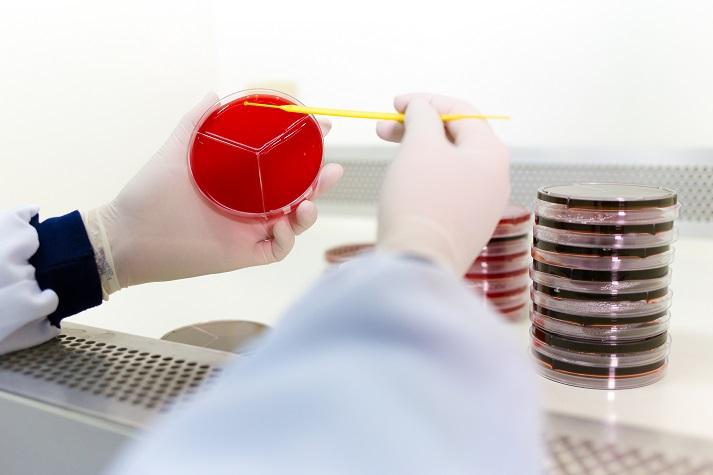

Unidade Matriz
Valores exclusivos para usuários BUKMED
Cadastro gratuito e sem mensalidade Solicite o orçamento pelo Whatsapp e pague apenas no dia do exameInformações sobre Unidade Matriz
O Laboratório MIL, fundado em 1984 em Taubaté, é referência em medicina laboratorial, atuando de forma ampla nas áreas de análises clínicas, microbiologia e diagnóstico laboratorial. Com mais de 30 anos de atuação, consolidou-se pelo apoio eficiente à diagnose médica, unindo experiência, tecnologia e credibilidade.
Realiza uma grande variedade de exames laboratoriais, incluindo análises bioquímicas, hormonais, imunológicas, microbiológicas e testes especializados, atendendo diferentes necessidades clínicas com precisão. Conta com estrutura moderna, equipe qualificada e recursos que facilitam o dia a dia do paciente, como acesso online aos resultados e processos que garantem agilidade no atendimento.
O atendimento é pautado na qualidade, segurança e humanização, com atenção em cada etapa do processo. Com investimento contínuo em tecnologia e melhoria dos serviços, o laboratório entrega resultados confiáveis e rápidos, contribuindo de forma consistente para o cuidado com a saúde e suporte às decisões médicas.
Valores especiais pela Bukmed!
Veja Fotos Unidade Matriz
Valores exclusivos para usuários BUKMED
Cadastro gratuito e sem mensalidade Solicite o orçamento pelo Whatsapp e pague apenas no dia do exameEspecialidades Médicas
- Anestesista
- Angiologista / Vascular
- Avaliação Neuropsicologica
- Cirurgião geral
- Endocrinologia
- Endocrinologia Pediátrica
- Fisioterapia
- Fisioterapia - ABA
- Fisioterapia e Psicomotricidade
- Fonoaudiologia ABA
- Ginecologia / Obstetrícia
- Integração Sensorial
- Médico da Família
- Neuropediatria
- Neuropsicologia
- Neuropsicopedagogia
- Nutrologo
- Oftalmopediatria e estrabismo
- Oncologista
- Veja todas as especialidades